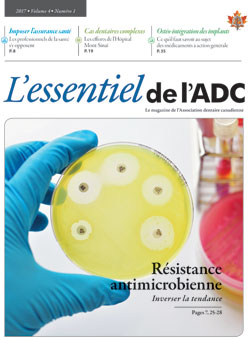

L’essentiel de l’ADC est la publication imprimée officielle de l’ADC, offrant un dialogue entre l’association nationale et la communauté dentaire. Le magazine sert ŕ informer les dentistes au sujet d’actualités, de nouvelles cliniques et d’enjeux pertinents ŕ la profession.
Tarifs et spécificités pour les publicités et les petites annonces sont disponibles dans
le dossier média de l’ADC pour 2026.
Soumettez votre demande d’insertion d’annonce ici.
Contact: Michelle Bergeron, Spécialiste des publications : mbergeron@cda-adc.ca
Volume 13 • 2026
 |
Numéro 2 |
|
|
|
||
|
|
|
Volume 12 • 2025
Volume 11 • 2024
Volume 10 • 2023
Volume 9 • 2022
Volume 8 • 2021
Volume 7 • 2020
Volume 6 • 2019
Volume 5 • 2018
Volume 4 • 2017
Volume 3 • 2016
Volume 2 • 2015
Volume 1 • 2014
ISSN 2292-7395 (version électronique)